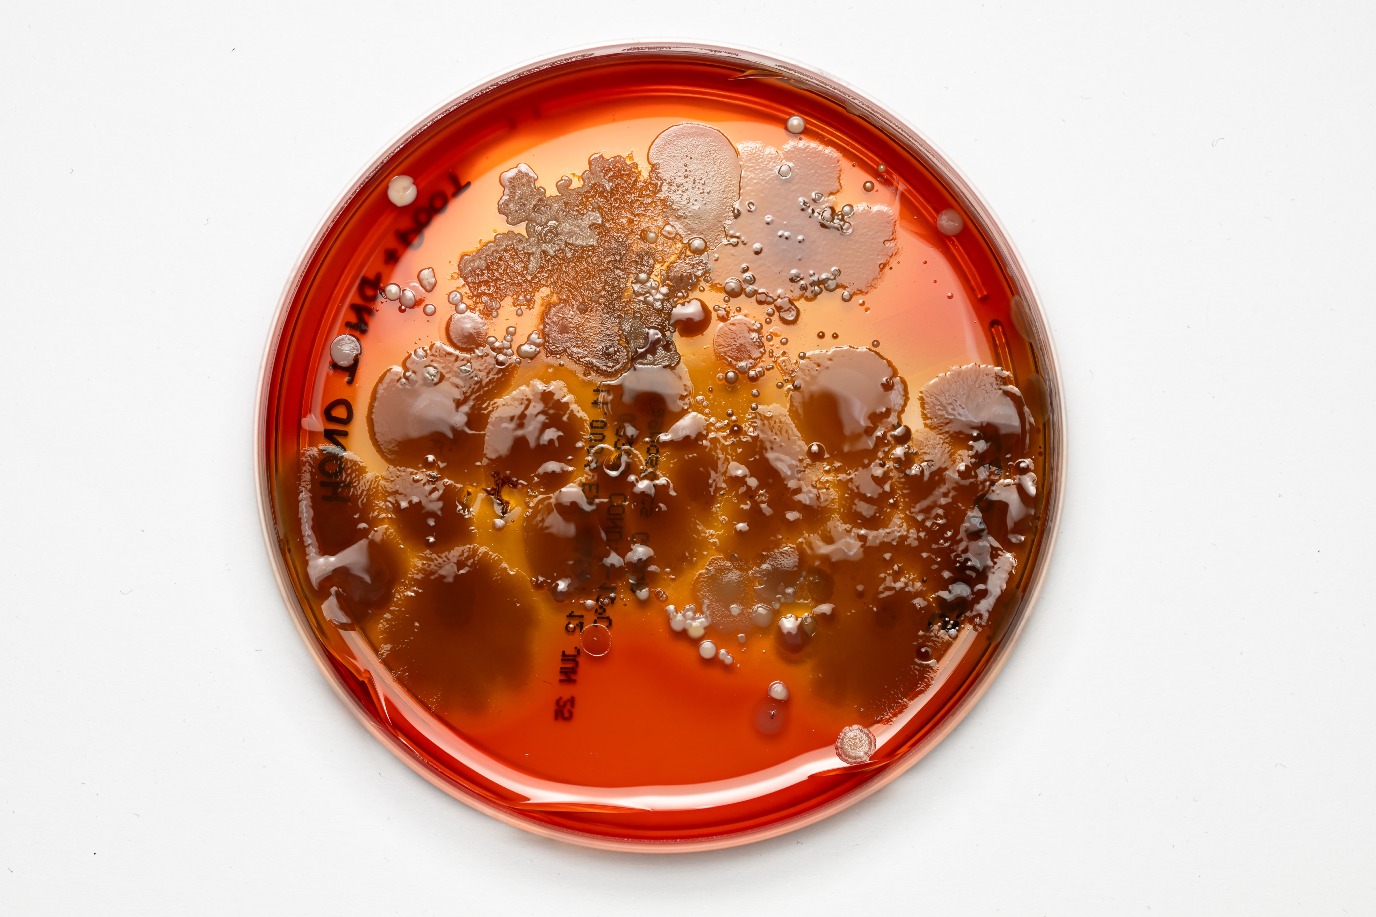

Weekend van de Wetenschap met Melanie During en meer


Het is weer Weekend van de Wetenschap en wij pakken groots uit! Kom langs en laat je
verwonderen door workshops, proefjes en
inspirerende verhalen. Ontdek, leer en beleef
samen hoe fascinerend wetenschap kan zijn.
Dit mag je niet missen:
- Melanie During neemt je mee naar de tijd van de dinosauriërs
- Beleef de wereld door de ogen van trekvogels met BirdEyes
- Stap in VR en volg de reis van je waterfles met
Omrin
- Ontmoet bacteriën van héél dichtbij – en neem er eentje mee naar huis
- Ontdek wonderlijke dieren van ver en dichtbij met Bert Natuur
Voor iedereen van 8 tot 88 jaar: kom kijken, doen, en ontdekken!
Zien we je op 4 oktober?
Melanie During - Alles over dino's
Inloop: 10:30 - 11:00
Tijd: 11:00 - 12:00
Melanie During is paleontoloog en weet alles van dino’s. Zij doet samen met veel andere experts onderzoek naar de gevolgen van de meteorietinslag waardoor de dinosauriërs plotsklaps bijna allemaal uitstierven.
Dr. Melanie During is vertebratenpaleontoloog en gepromoveerd aan de Universiteit van Uppsala in Zweden. Ze onderzoekt uitgestorven werveldieren, oftewel dieren met een ruggengraat. Binnen deze discipline specialiseert zij zich vooral in het onderzoeken van belangrijke evolutionaire gebeurtenissen, zoals de overgang van vis naar landdier, van landdier naar zeebewoner of van landdier naar zeebewoner of van landdier naar vliegend dier. Anderzijds houdt ze zich ook graag bezig met uitstervingen. Zo ontdekte ze in 2022 dat de meteoriet die de dinosauriërs deed uitsterven, in de lente moet zijn ingeslagen. Melanie’s boek De Laatste Lente van de Dinosauriërs verscheen op 26 september 2023.
Dat wil je toch niet missen? Wees erbij!
Tresoar – ontdek jouw stamboom
Duur workshop: 60 minuten
Tijd:
12:15 – 13:15
13:30 – 14:30
14:45 – 15:45
Wil je weten wat jouw familiegeschiedenis is? Tijdens deze workshop helpen we je met je zoektocht en leer je hoe stamboomonderzoek werkt. Want hoe begin je eigenlijk? Welke bronnen zijn er en hóe zoek je dan? Hoe orden je vervolgens de wirwar aan gevonden gegevens?
Ga aan de slag en leer hoe je eigen stamboom kan worden aangekleed.
Geschikt voor alle leeftijden!
Benodigdheden:
-neem je eigen laptop, I-pad of tablet mee
-je hebt enige computervaardigheden
-neem graag de gegevens (personalia) van je ouders en grootouders mee, zoals geboortedatum (en plaats), trouwdatum en eventuele overlijdensdatum (en plaats).
Dan kun je écht aan de slag met het maken van je persoonlijke stamboom!
We zien je graag bij deze praktische workshop, die gegeven wordt door Tresoar. Er is ruimte voor 15 deelnemers per keer, vol = vol.


24Terra - 'Kweek bacteriën met je handafdruk!'
Tijd: 12:00 - 16:00 (doorlopend)
Er leeft van alles om je heen — ook al zie je het niet! In deze spannende activiteit ontdek je de onzichtbare wereld van micro-organismen.
Maak kennis met piepkleine wezentjes zoals beerdiertjes uit de dakgoot, pantoffeldiertjes uit de sloot en bacteriën in yoghurt. Je maakt zelfs een afdruk van je eigen hand… en kweekt daarmee je eigen bacteriën om thuis te bekijken!
-
Voor kinderen van 6 tot 14 jaar
-
Zelf doen, zelf ontdekken — en leren hoeveel leven er schuilgaat op één hand!
Bert Natuur - Natuurhelden van Eigen Bodem (met echte dieren!)
Tijd: 12:00 - 16:00 (doorlopend)
Vaak zijn natuurliefhebbers bezig met tropische dieren... maar hoe zit het met onze eigen natuur? Papegaaien en panda’s zijn leuk, maar de echte natuurhelden leven gewoon om de hoek!
In deze activiteit ontdek je hoe bijzonder de Nederlandse natuur is en waarom die méér aandacht verdient.
Laat je boeien door exotische dieren, zoals slangen spinnen en varanen! En kom dan kijken hoe het écht zit met de natuur in Nederland!
Voor nieuwsgierige kinderen en hun ouders. Met foto’s, weetjes en aandacht voor jouw eigen omgeving!


Reina Visser - 'Duik in de wereld van zaden!'
Tijd: 12:00 - 16:00 (doorlopend)
Hoe zien zaden eruit? Waar komen ze vandaan? En… hebben paddenstoelen eigenlijk ook zaden?
In deze vrolijke ontdekkingstocht ga je zaden bekijken, voelen én ermee spelen.
Ontdek of zaden echt in een hotel wonen (of toch niet?) en stel al je vragen over hoe planten groeien.
-
Voor nieuwsgierige kinderen van 4 tot 12 jaar
-
Met echte zaden, leuke weetjes en verrassingen uit de natuur!
Ga je mee op ontdekkingstocht?
Omrin VR Waste Experience - De Reis van een Plastic Fles
Tijd: 12:00 – 16:00 (doorlopend)
Van frisdrankfles naar nieuwe grondstof — ontdek wat er gebeurt nadat jij je fles inlevert! Met een VR-bril op je hoofd stap je letterlijk ín het avontuur en volg je iedere stap van het recyclen alsof je er zelf bij bent. Je ziet hoe jouw fles wordt gesorteerd, verwerkt en omgetoverd tot een nieuw product.
Loop mee in dit interactieve mini-avontuur, speciaal voor kinderen die nieuwsgierig zijn naar wat er achter de schermen gebeurt. Het voelt alsof je zelf in de fabriek staat, de machines ziet draaien en van heel dichtbij ervaart hoe afval een tweede leven krijgt. Leren, spelen en beleven komen hier samen!

Fryske Akademy – Ontrafel de geheimen van taal en cultuur
Tijd: 12:00 -16:00 (doorlopend)
Hoeveel talen hoor jij op een dag? En wist je dat talen families hebben — net als mensen? Hoewel we de hele dag door taal gebruiken, staan we daar helemaal niet bij stil. Ook denken we niet vaak na over wat er in de bodem begraven ligt diep onder onze voeten. Wie heeft hier eigenlijk vroeger gewoond — en wat hebben ze achtergelaten? Kom langs om samen met taalwetenschappers en historici van de Fryske Akademy deze geheimen van taal en cultuur te ontrafelen! Steek je handen maar uit de mouwen en kom geheimtaal ontcijferen, gedichtjes schrijven, en schatgraven!
Voor nieuwsgierige kinderen van alle leeftijden (ook ouders, en opa’s/oma’s!) Je hoeft geen Fries te kunnen spreken om mee te doen, alle talen zijn welkom!


Friso Timmenga (RUG) - "Het Grote Dilemma-spel"
Tijd: 13:00 - 13:30 (eenmalig)
Durf jij het aan? Los de Superdilemma’s op! Wat is belangrijker: vrijheid of veiligheid? Altijd doen wat volwassenen zeggen… of zelf beslissen?
In deze interactieve sessie neemt filosoof Friso Timmenga je mee in spannende keuzes en lastige vragen waar niet altijd één juist antwoord op is. Denk mee, kies jouw kant, en praat met andere kinderen over wat jij eerlijk vindt! Durf jij te zeggen wat jij belangrijk vindt? Kom dan naar Superdilemma’s en laat je stem horen!
Voor nieuwsgierige denkers van 9 tot 16 jaar (ouders mogen natuurlijk ook luisteren ;))Met echte dilemma’s, stemmen, discussies en verrassende inzichten!
BirdEyes - Ontdek hoe grutto's met elkaar praten
Tijd:
12:30 - 12:50
12:50 - 13:10
13:10 - 13:30
13:30 - 13:50
Pauze: 13:50 - 14:10
14:10 - 14:30
14:30 - 14:50
14:50 - 15:10
15:10 - 15:30
15:30 - 15:50
Grutto’s kletsen de hele dag door, ze maken minstens 27 verschillende geluiden. OndÅ™ej Belfín onderzoekt de taal van de grutto’s en kan je vertellen wat al die verschillende geluiden betekenen. ‘Pas jij even op de kinderen’ bijvoorbeeld, of ‘Opletten! Er komt een roofdier aan!’. Bekijk zijn mooie video van grutto’s en hun kleintjes en luister zelf goed. Kun jij grutto’s verstaan?

Ga op de foto als een wetenschapper!
Tijd: 12:00 -16:00 (doorlopend)
Heb jij altijd al wetenschapper willen zijn? Dat kan vandaag! Je hebt misschien al een beetje een beeld of zelfs een voorkeur voor een bepaald wetenschappelijk thema. Hoe leuk is het dan om de dag compleet te maken door op de foto te gaan als wetenschapper in jouw interessegebied!? Astronaut, politicoloog, maritiem onderzoeker, taalwetenschapper, econoom, filosoof, of iets heel anders? Ga op de foto en ontdek wat jij leuk vindt!


Pelin Gül - "Eerlijk of niet? Jij beslist!"
Tijd: 12:00 - 16:00
Tijdsduur: 5- 10 minuten per keer
Was dat wel eerlijk? Speel, oordeel en ontdek met mensen, dieren en robots!
Kom naar deze superleuke en interactieve activiteit waar jij bepaalt wat goed en fout is! Met behulp van poppenverhalen over een meisje, een puppy en een robot, gaan we samen onderzoeken:
-
Wanneer is iets écht verkeerd?
-
Maakt het uit wie het doet — een mens, dier of robot?
-
En wat als iemand het niet expres deed?
Speel mee, geef je mening met grappige emoji’s, en ontdek of jij en je ouders het met elkaar eens zijn!
Voor kinderen van 7 tot 16 jaar (ouders mogen ook meedoen!)
Doe mee en verdien een leuke verrassing!
Tijdens deze activiteit wordt Engels gesproken. De getoonde materialen bevatten een mix van Engels en Nederlands.

Germain Abdul-Rahman (RUG) Is Tech Fair? Let’s Talk Ethics
Time: 14:00 - 14:20 (one time only)
Technology isn’t just tools and gadgets — it also reflects choices, values, and sometimes hidden biases. In this interactive session, we’ll explore how tech affects people differently, and why that matters.
Why is violent gameplay often fine, but things like racism or hate speech cross the line? And what about real-world tech, like soap dispensers that don’t work on all skin tones, or AI that wrongly predicts who might commit a crime?
Using short videos and real-life examples, we’ll dive into the big questions: Who decides what’s fair? Who gets left out? And how can we make tech more equal for everyone?
This is a session for anyone who’s ever asked, “Wait... is that really okay?”
The session is in English and it is one time only. It will take about 20 minutes.

Tim Huiskes (RUG) - Veilig op
vakantie in een veranderend klimaat
Tijd: 15:00 - 15:45 (eenmalig)
Hittegolven aan de Middellandse Zee, smeltende sneeuw in de Alpen en overstromingen in Limburg: het zijn allemaal tekenen dat ons klimaat verandert. Zelfs de plekken waar we graag op vakantie gaan, krijgen ermee te maken. Maar wat betekent dat
eigenlijk voor onze vakanties in de toekomst? En waar kun je nog veilig en met plezier naartoe?
Onderzoeker Tim Huiskes neemt je in zijn lezing mee op een spannende reis langs vakantiebestemmingen dichtbij en ver weg. Hij laat zien hoe klimaatverandering invloed heeft op onze favoriete plekken, en hoe landen en regio’s zich voorbereiden om jou als reiziger toch een veilige en fijne vakantie te bieden. Van de Alpen tot aan Friesland: je ontdekt verrassende feiten, slimme oplossingen en misschien ook nieuwe bestemmingen om van te dromen!
Onze partners tijdens het Weekend van de
Wetenschap zijn:



